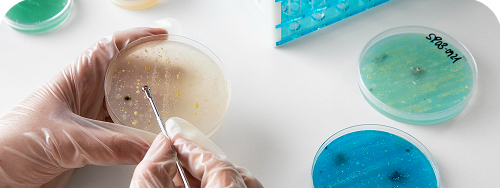
análisis bioquímico

Conoce nuestros exámenes
En Laboratorio FEROSOR realizamos análisis veterinarios precisos y oportunos que apoyan el diagnóstico, la prevención de enfermedades y la productividad animal.

Análisis
Hematológicos
Evalúa el estado fisiológico y patológico a través del estudio de los componentes sanguíneos.
Ver más
Análisis
de orina
Permite detectar precozmente diversas enfermedades y apoyar el diagnóstico y seguimiento clínico veterinario.
Ver más
Análisis
microbiológicos
Detecta infecciones y garantizar la calidad e inocuidad del producto.
Ver más
Análisis
Parasitológicos
Permiten detectar parásitos, prevenir zoonosis y garantizar el bienestar animal y comunitario.
Ver más
Análisis
Serológicos
Clave para controlar y erradicar enfermedades, garantizando la sanidad, el bienestar y el acceso a mercados seguros.
Ver más
Análisis
Agroquímicos
Permiten optimizar la nutrición animal, reducir costos y mejorar la productividad.
Ver más¿Por qué Laboratorio FEROSOR?
Más de 10 años de experiencia en el sector
Tecnología moderna y resultados precisos
Equipo experto en diversas áreas clínicas
Alianzas estratégicas para soluciones completas
Contacto
En Laboratorio FEROSOR estamos comprometidos con entregar un servicio cercano y oportuno. Si necesitas más información sobre nuestros análisis, cotizar un servicio o resolver tus dudas, completa el formulario y nuestro equipo te responderá a la brevedad










